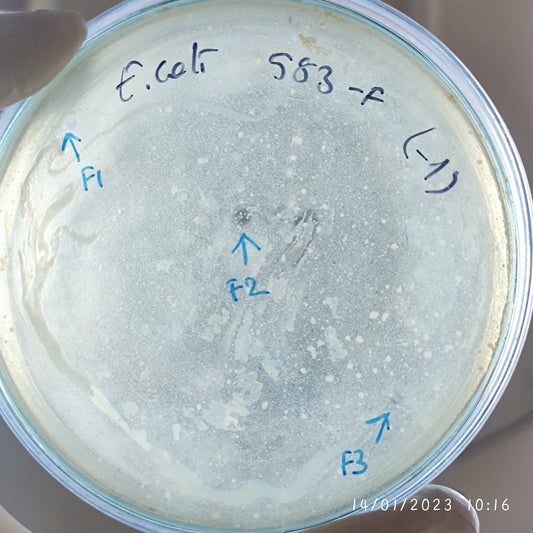
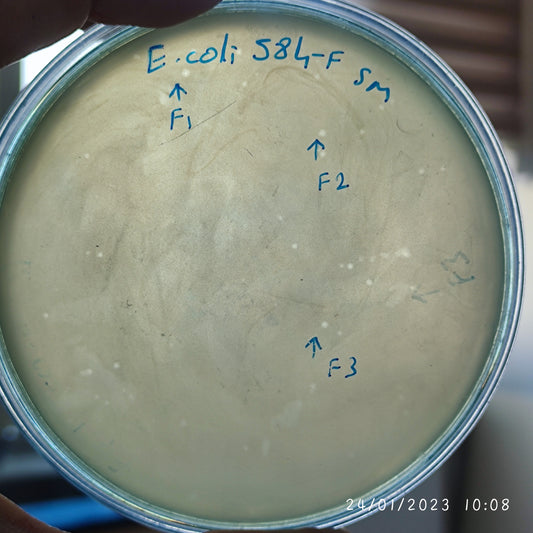
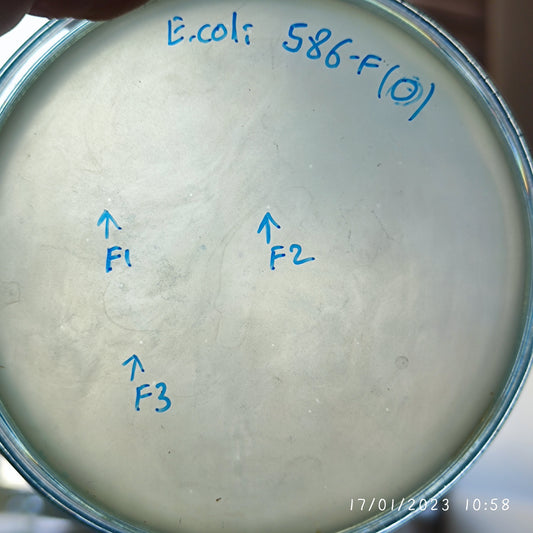
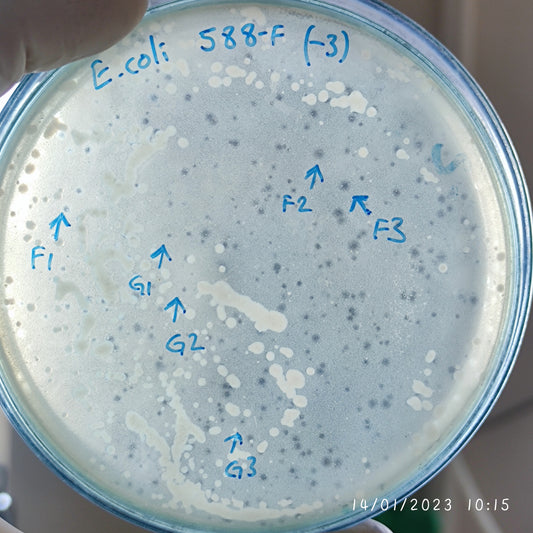
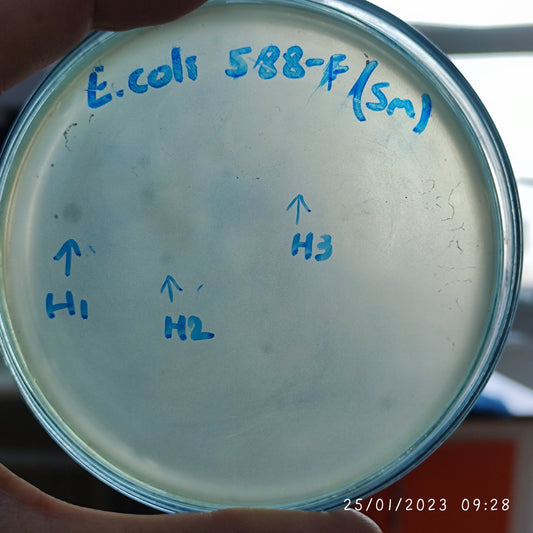
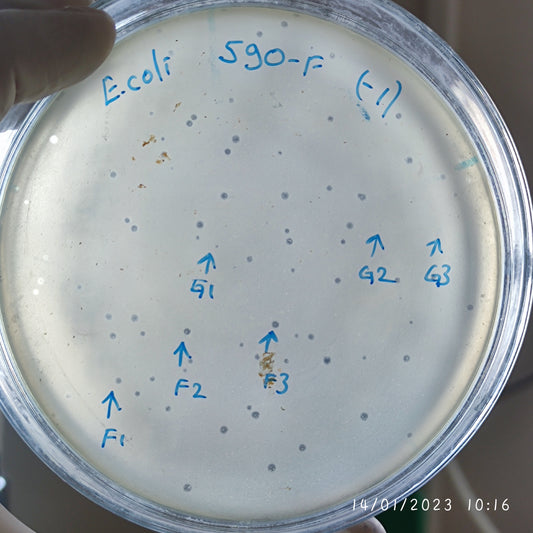
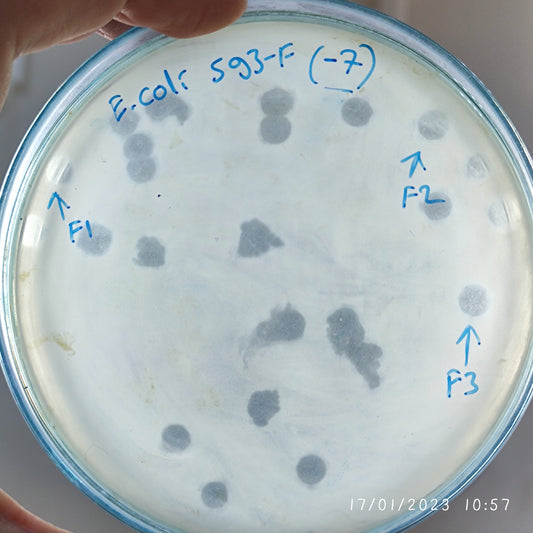
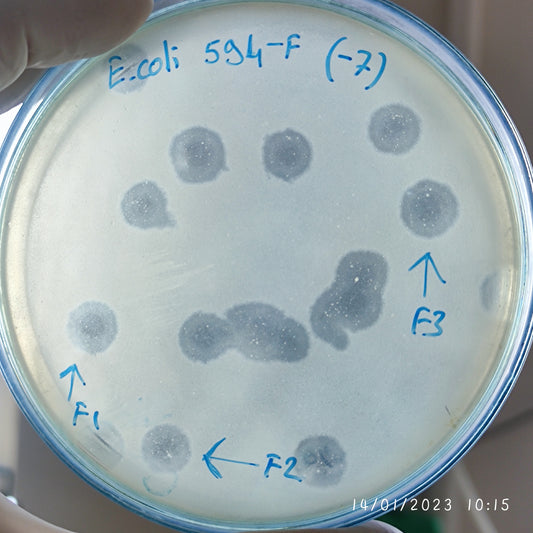
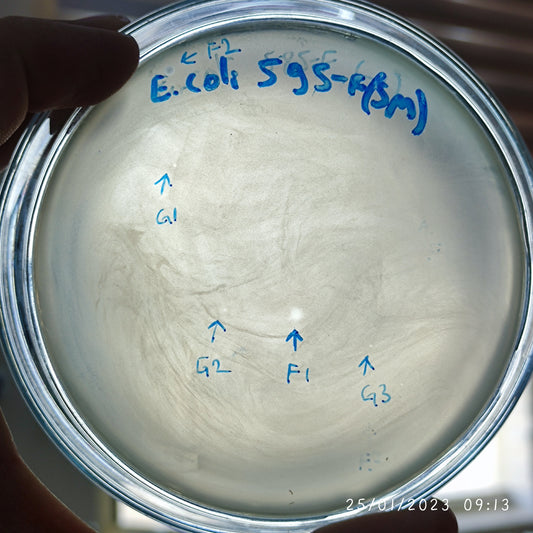
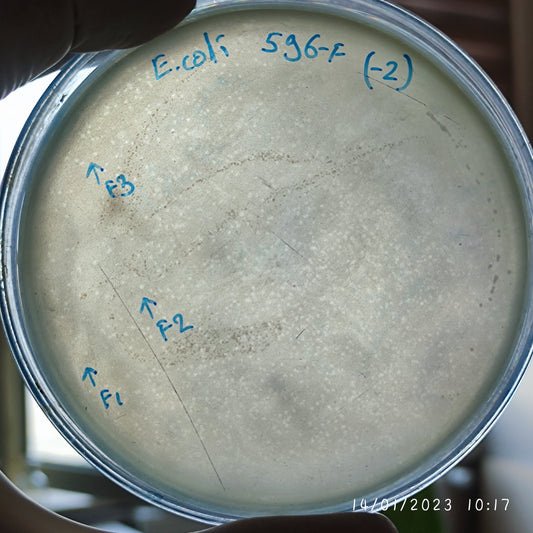
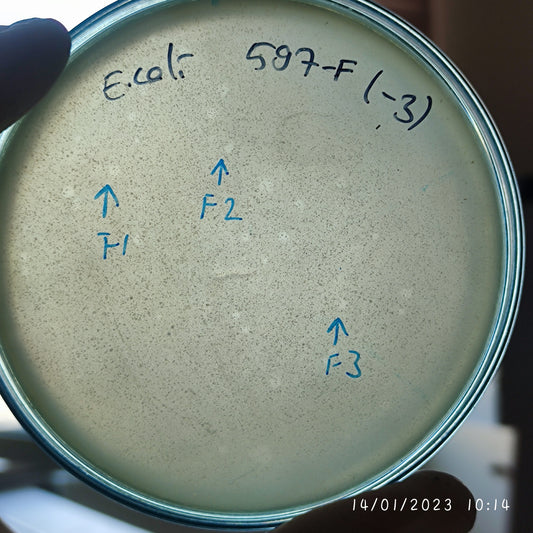

-
Escherichia coli bacteriophage 100583F
Regular price $600.00 USDRegular priceUnit price per -
Escherichia coli bacteriophage 100584F
Regular price $750.00 USDRegular priceUnit price per -
Escherichia coli bacteriophage 100585F
Regular price $500.00 USDRegular priceUnit price per -
Escherichia coli bacteriophage 100586F
Regular price $500.00 USDRegular priceUnit price per -
Escherichia coli bacteriophage 100588F
Regular price $500.00 USDRegular priceUnit price per -
Escherichia coli bacteriophage 100588G
Regular price $500.00 USDRegular priceUnit price per -
Escherichia coli bacteriophage 100588H
Regular price $650.00 USDRegular priceUnit price per -
Escherichia coli bacteriophage 100590F
Regular price $500.00 USDRegular priceUnit price per -
Escherichia coli bacteriophage 100590G
Regular price $500.00 USDRegular priceUnit price per -
Escherichia coli bacteriophage 100592F
Regular price $670.00 USDRegular priceUnit price per -
Escherichia coli bacteriophage 100593F
Regular price $750.00 USDRegular priceUnit price per -
Escherichia coli bacteriophage 100594F
Regular price $750.00 USDRegular priceUnit price per -
Escherichia coli bacteriophage 100595F
Regular price $750.00 USDRegular priceUnit price per -
Escherichia coli bacteriophage 100595G
Regular price $600.00 USDRegular priceUnit price per -
Escherichia coli bacteriophage 100596F
Regular price $500.00 USDRegular priceUnit price per -
Escherichia coli bacteriophage 100597F
Regular price $600.00 USDRegular priceUnit price per